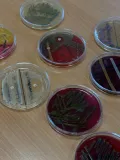

Publikováno: 02.10.2025
Naše fakulta už podruhé spoluorganizovala Noc vědců na Gymnáziu Petra Bezruče ve Frýdku-Místku, které letos slaví 130 let od svého vzniku.
Chodbami místeckého gymnázia prošlo zhruba 800 návštěvníků. Ve dvou učebnách je čekala spousta chemie v praxi – od zapalování ohně reakcí hypermanganu s kyselinou sírovou přes využití červeného zelí jako přírodního indikátoru pH až po pohled do mikroskopu na plísně a kvasinky.
Kromě pestrých ukázek chemických pokusů se zájemci seznámili také s nabídkou studijních programů Fakulty chemicko-technologické Univerzity Pardubice.
Děkujeme všem, kteří za námi na Noc vědců přišli, a těšíme se opět na viděnou.